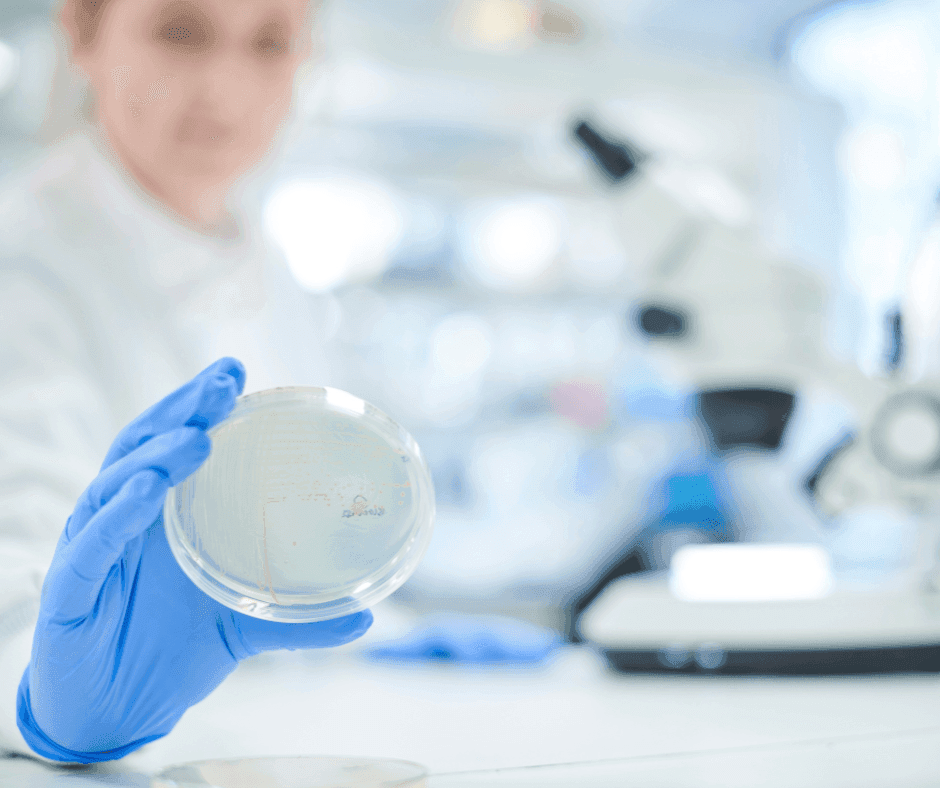

Nieuwe modelsystemen voor hersenstamtumoren
Artsen kunnen tumoren in de hersenstam moeilijk behandelen. Hierdoor is de gemiddelde levensverwachting van kinderen met deze ziekte beperkt tot negen maanden. Om meer kennis te verzamelen en zo betere behandelingen te ontwikkelen, ontworpen onderzoekers van het Amsterdam UMC nieuwe methodes om hersenstamkanker te onderzoeken.

Diffuus intrinsiek ponsglioom
Diffuus intrinsiek ponsglioom (DIPG) is een zeer agressieve hersenstamtumor die voornamelijk bij kinderen voorkomt. In Nederland krijgen ongeveer 10-15 kinderen per jaar DIPG. Hierdoor is onderzoek naar deze ziekte moeilijk. Tegelijkertijd is onderzoek dringend nodig, aangezien de vooruitzichten voor kinderen met dit type hersenstamtumor het slechtst zijn van alle soorten kinderkanker. Dit komt doordat de tumor moeilijk te bereiken is met chemotherapie of bij een operatie.
Over het onderzoek
Modelsystemen zijn dieren of cellen die onderzoekers gebruiken om processen in het lichaam, zoals het ontstaan van kanker, beter te begrijpen. Deze kennis kan vervolgens toegepast worden op mensen. De onderzoekers ontwikkelden vier modelsystemen met gedoneerde tumorcellen van kinderen die overleden aan DIPG. Tijdens het ontwikkelen van een van deze modellen in dieren vonden de onderzoekers iets onverwacht. Nadat ze de tumorcellen van de kinderen in de hersenstam van muizen plaatsten, ontstonden er nieuwe tumoren in cellen die afkomstig waren van de muizen. Dit wijst erop dat de DIPG-tumorcellen kanker veroorzaken bij muizen. Begrijpen waarom en hoe dit gebeurt is belangrijk en geeft mogelijk inzicht in hoe DIPG ontstaat en hoe de ziekte voorkomen kan worden.
Toekomst
Onderzoekers in en buiten Nederland gebruiken inmiddels de modelsystemen om de ontwikkeling van tumorcellen te bestuderen, nieuwe medicijnen te testen en de beste manier van het toedienen van medicijnen te bepalen. Vervolgens kunnen ze testen of deze medicijnen werken bij kinderen met DIPG.
Onderzoeksnummer: 69
Centrum: Amsterdam UMC (locatie VU)
Startjaar: 2011
Looptijd: 3 jaar
Totale kosten/bijdrage KiKa: € 269.500





